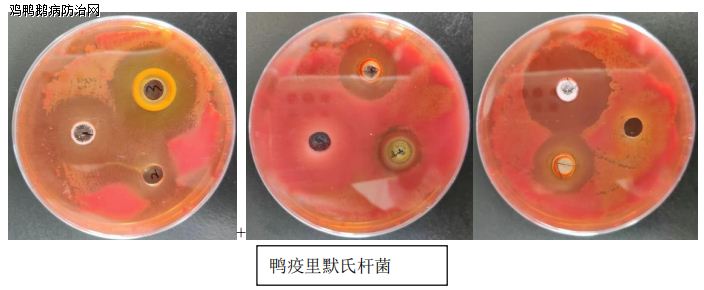

鸡鸭鹅病防治网联合驰骋中兽医研究所共同分享:
因刚才有一位朋友给我打电话,聊到换羽期不敢通风,不敢降温度,不敢扩硼,啥也不敢,非常小心。因为都在讲换羽期容易发病。
其实鸭子所谓的两次换预期都是生理现象,鸭子从十二三天开始掉绒毛,有些发育快的鸭群,从八九天就开始掉绒毛,一直到三十四五天,大翎长出来大这个阶段,它都在换羽。
为什么要说16/7天、27/8天是2次换羽期,容易出问题呢?这两个阶段确实容易出问题。开篇点题,这两个关键时期,预防病毒病、浆膜炎等用驰骋奇珍+好得快+生命核能,在换羽前2-3天用上,这样做效果非常理想。魏老师温馨提醒,13939027068 成龙在路上 13838248089
1:免疫空白期
15-20天之间,正是鸭子的免疫空白期。卵黄里带来的母源抗体,到15天基本消耗没了。绝大部分的鸭子去测抗体是基本上是没有的。
咱们打的油苗或者野毒感染产生的抗体,并没有完全的起来。油苗抗体基本上要到20天以后才能够达到有效的抗病低度。15-20天之间鸭子体内的抗体水平是非常低的。
2:应激集中期
而这个阶段又是很多操作应激的集中期。扩群、换料、增加通风等应激操作都集中在这个阶段。
3:快速发育期
而且这个阶段也是鸭子快速生长的阶段,主要是内脏发育,到20天鸭子内脏功能达到80%,基本成型。内脏发育快,鸭子对矿物质、微量元素、优质蛋白质需求与消耗就比较大。体质较差,也容易出现营养类的问题。

这个阶段应激集中,抗体水平又低,营养消耗厉害,都导致鸭子容易发病。但是容易发病并不代表着咱们不能去做各种各样的操作。该降温度的降温度啊,该通风的通风,特别是通风。稳定可以适当保持稳定,但是通风量该加上去的就要加上去,因为通风量牵扯折供氧量。鸭子快速发育,大量消耗营养,对氧气的消耗也是增长极快。这个阶段如果不敢通风出现捂棚,那后面的养殖就很困难了。
所以这个阶段咱们温度方面可以相对保守,但是通风量该加上去的就要加上去,管理操作尽可能的减各种应激,就可以了。
在这个阶段可以适当的给鸭子使用提免、调节体质、促进消化的药品如驰骋奇珍+好得快+生命核能,并且要给鸭子额外补充营养。
而27/8天换羽期发病期,如果前期温度通风能够控制的好,温度能降下来,通风量能涨上去,就不易出现高发病的问题。

出现高发病的情况,多少前期捂棚厉害通风量没有加上去。到了30天前后就是最容易出问题的。
1:内脏损伤累积
因为鸭子前期捂棚厉害,鸭子长期处于闷热慢性缺氧的环境中,内脏负担与损伤是非常厉害的。一般积累到接近30天的时候,内脏负担容易达到瓶颈,而出现发病问题。
2:环境病原体累积
捂棚厉害的鸭棚,棚舍内的有害气体、毒素、病原体经过近一个月的累积也容易达到激发疾病的阈值。
3:快速生长抗病力差
25-30日龄前后是骨架发育成型的阶段,对矿物质营养消耗也是厉害,体质也相对差,管理上不注意也容易出问题。
所以说前期把温度降下来,通风量跟上去,前期净化的免疫抑制病、细菌要净化好。这个阶段就不容易出问题。
所谓的换羽期易发病和鸭子整体的抗体水平和棚内的病原体有害物质的积累,以及和鸭子内脏的负担积累是有关系的。而不是绝对化的。
新型无抗纯中药制剂——驰骋养殖安(杜仲叶提取物)代替抗生素添加剂,在减少产蛋鸡大肠杆菌(长期使用养殖安对家禽与水禽体内大肠杆菌的抑制率达98.8%以上)、沙门氏菌等细菌病的发生,抗球虫(定期使用0.75%养殖安,可大大避免球虫病、过料等问题的发生);提高产蛋鸡的抗病能力,发挥产蛋鸡的高产性能等方面已得到了较好的推广应用效果,并且在使用中取得了明显的经济效益和良好的社会效益。种鸡、种鸭:对种蛋合格率、孵化率、受精率、死陶率等效果显著,用养殖安1次见效,用1月叫好,用2个月后让您的种禽无可挑剔!!!无抗养殖保健专业技师:魏老师在现场13939027068 成龙在路上 13838248089





发表评论共有0访客发表了评论
暂无评论,快来抢沙发吧!